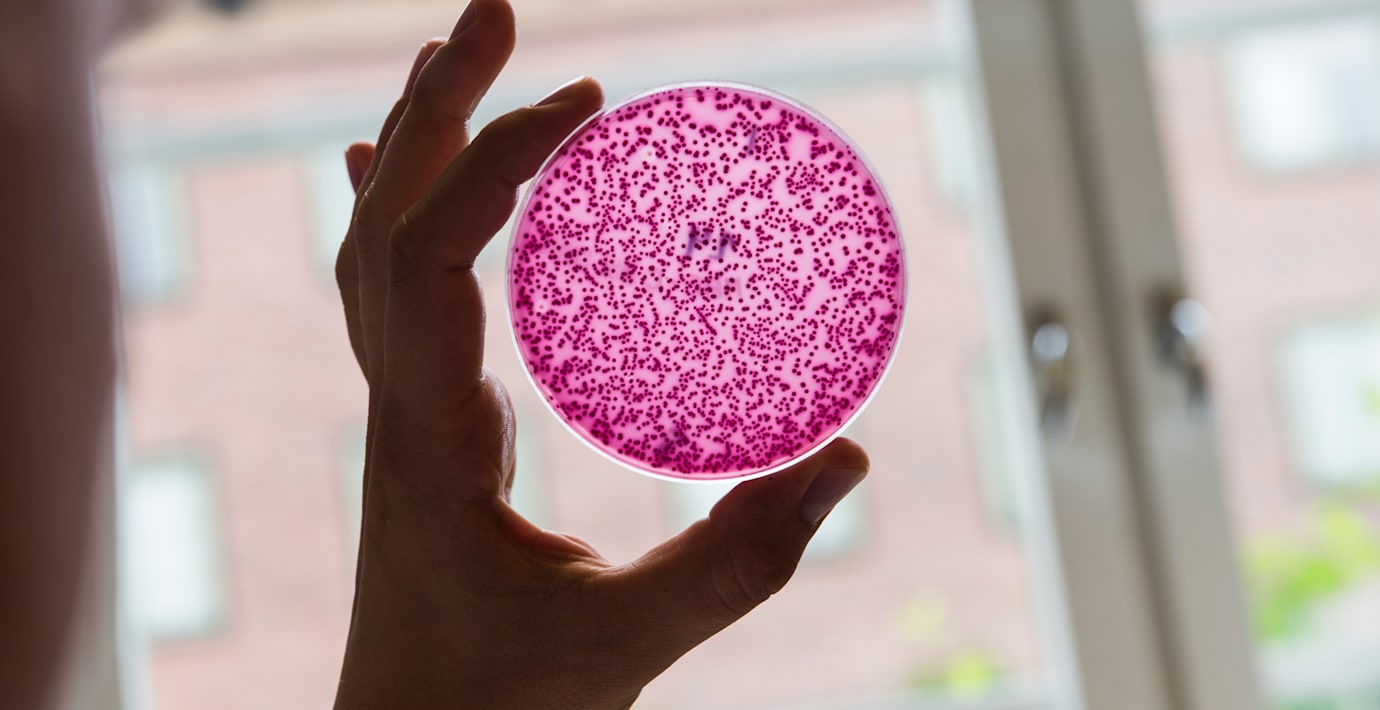

Antibiotika till barn har nästan halverats på 10 år
Mellan 2007 och 2017 minskade förskrivningen av antibiotika till barn med 43 procent. Det visar nya siffror från Socialstyrelsen enligt flera medier.
– Gällande barn har det funnits en mycket större andel onödig förskrivning, säger Malin Grape på Folkhälsomyndigheten till Nyhetsbyrån Siren.
Förskrivningen till befolkningen i stort har minskat med 23 procent på tio år. För personer över 80 går utvecklingen betydligt långsammare, i den gruppen har användningen minskat med bara nio procent.
Bäst på att dra ner på antibiotikan är Västra Götaland län och Hallands län, rapporterar SVT Nyheter Halland.
I dag börjar den Internationella antibiotikaveckan som har syftet att uppmärksamma problemet med antibiotikaresistens.
Omni är politiskt obundna och oberoende. Vi strävar efter att ge fler perspektiv på nyheterna. Har du frågor eller synpunkter kring vår rapportering? Kontakta redaktionen



